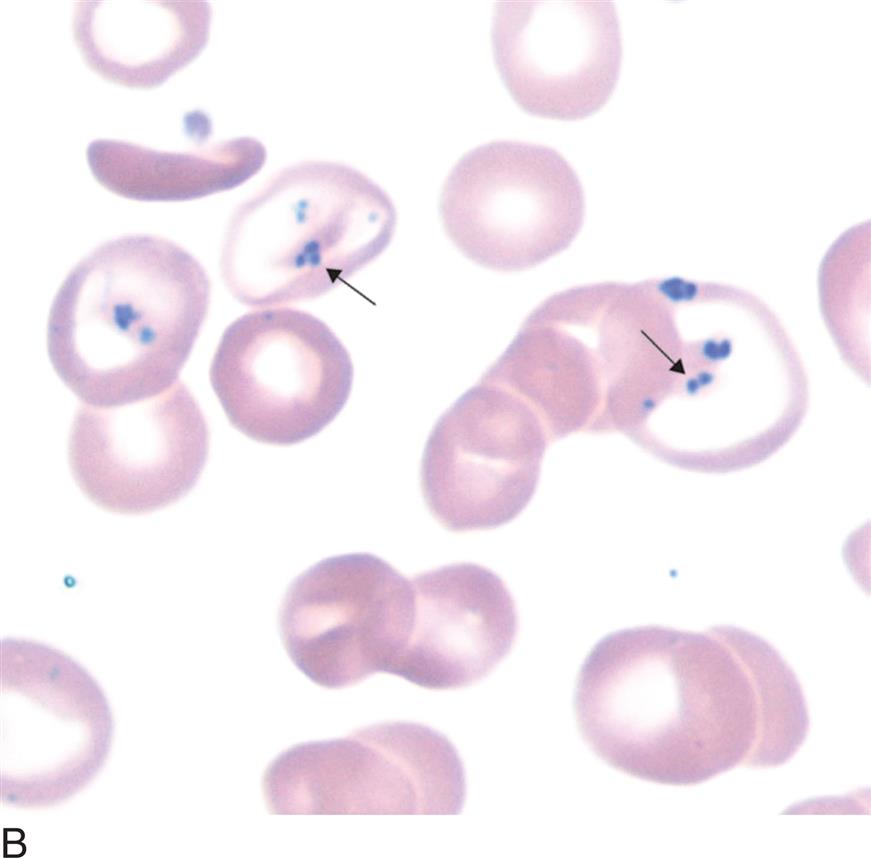
image

COLOR: Dark blue to purple
SHAPE: Round to oval
SIZE: 0.5 to 1.5 μm
NUMBER PER CELL: Usually 1; may be multiple
COMPOSITION: DNA (deoxyribonucleic acid)
ASSOCIATED WITH: Splenectomy, hyposplenism, megaloblastic anemia, hemolytic anemia
COLOR: Dark blue to purple
SHAPE: Fine or coarse punctate granules
NUMBER PER CELL: Numerous with fairly even distribution
COMPOSITION: RNA (ribonucleic acid)
ASSOCIATED WITH: Lead intoxication, thalassemia, abnormal heme synthesis
COLOR: Light blue
SHAPE: Fine irregular granules in clusters
NUMBER PER CELL: Usually one cluster; may be multiples; often at periphery of cell
COMPOSITION: Iron
ASSOCIATED WITH: Splenectomy, hemolytic anemia, sideroblastic anemia, megaloblastic anemia, hemoglobinopathies
COLOR: Dark blue to purple
SHAPE: Loop, ring, or figure eight; may look like beads on a string
NUMBER PER CELL: 1 to 2
COMPOSITION: Thought to be remnants of mitotic spindle
ASSOCIATED WITH: Myelodysplastic syndrome, megaloblastic anemia
NOTE: This is a rare finding. May be confused with malaria (see Fig. 21.1A).
CELL: Anuclear immature erythrocyte
COMPOSITION: Precipitated RNA
NUMBER: Two or more per cell
COLOR: Dark blue
ASSOCIATED WITH: Immature erythrocyte
NOTE: Supravital stains are taken up by living cells.
CELL: Mature erythrocyte
COMPOSITION: Denatured hemoglobin
NUMBER: Single or multiple, generally membrane bound
COLOR: Dark blue to purple
ASSOCIATED WITH: Unstable hemoglobin, some hemoglobinopathies, some erythrocyte enzyme deficiencies (e.g., glucose-6-phosphate dehydrogenase)
CELL: Mature erythrocyte
COMPOSITION: Hemoglobin β chain tetramers
NUMBER: Multiple evenly dispersed inclusions described as “golf balls” or “raspberries”
COLOR: Dark blue
Table 12.1
+, Positive; 0, negative. DNA, Deoxyribonucleic acid; NA, not applicable; RNA, ribonucleic acid.